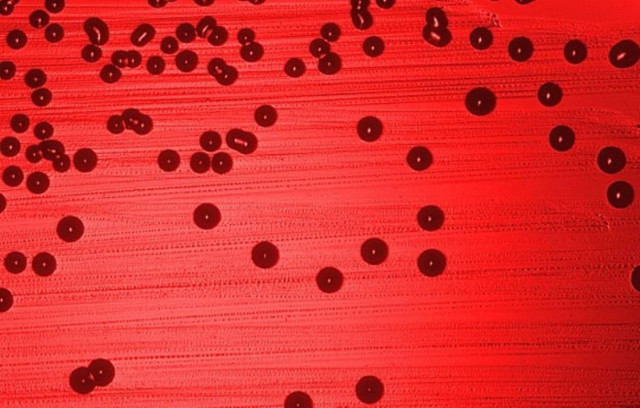
Φιλικοί ιοί vs εχθρικά βακτήρια

ΜΙΚΡΟΒΙΑ

Δείτε τι υπάρχει πάνω στο τιμόνι του αυτοκινήτου σας χωρίς να το γνωρίζετε
WHAT THE FACT
·
25.01.2016 - 18:14
Την επόμενη φορά που θα καθίσετε στη θέση του οδηγού και θα πάρετε το τιμόνι στα χέρια σκεφτείτε ότι... ακουμπάτε μία από τις πιο επικίνδυνες…

Έρευνα : Οι γενειάδες είναι τόσο βρώμικες όσο οι τουαλέτες
ΚΟΣΜΟΣ
·
01.01.2016 - 13:26
Ο μικροβιολόγος John GOLOBIČ, της Quest Diagnostics στο Νέο Μεξικό, που αναζηά για βακτήρια στις γενιάδες ανέφερε: «Γενικά δεν εκπλήσσομαι από πολλά πράγματα, αλλά αυτό…

Ποια είναι τα βακτήρια μας βοηθούν να χάσουμε βάρος
ΥΓΕΙΑ
·
06.12.2015 - 17:05
Νέα έρευνα αποκαλύπτει ότι δίαιτες «κομμένες και ραμένες» στα μέτρα μας, βασισμένες στα μικρόβια που υπάρχουν στο στομάχι μας είναι η λύση για ανθρώπους που…

Κίνδυνος για εκατομμύρια θύματα από ανθεκτικά μικρόβια
ΚΟΣΜΟΣ
·
11.12.2014 - 10:26
Μέχρι το 2050, περισσότερες από 10 εκατομμύρια ζωές θα χάνονται κάθε χρόνο παγκοσμίως, από ανθεκτικά στα φάρμακα μικρόβια, αν δε ληφθούν δραστικά μέτρα.

Γαλλία: Παγκόσμια απειλή η αντοχή των μικροβίων στα αντιβιοτικά
ΥΓΕΙΑ
·
16.02.2014 - 22:40
Η αυξανόμενη αντίσταση των μικροβίων στα αντιβιοτικά έχει γίνει μια απειλή σε πλανητική κλίμακα, η οποία λαμβάνεται πολύ στα σοβαρά από τις υγειονομικές αρχές που,…

Δε θα πιστεύετε πόσο βρόμικο είναι το τιμόνι του αυτοκινήτου!
ΑΥΤΟΚΙΝΗΤΟ
·
24.01.2014 - 09:24
Πάμπολλες έρευνες έχουν αποδείξει ότι στο τιμόνι του αυτοκινήτου μας υπάρχουν τόσα βακτηρίδια πάνω, που μία εικόνα από μικροσκόπιο θα μας σοκάρει.

Κανέλλη: Να μιλάτε 20-30 πόντους μακριά από το μικρόφωνο!!
ΠΟΛΙΤΙΚΗ
·
28.11.2013 - 15:20
Η Ζωή Κωνσταντοπούλου ξέρει να ανεβάζει καθημερινά τους τόνους….

Καινοτομία για την παραγωγή βενζίνης από τροποποιημένα μικρόβια
ΤΕΧΝΟΛΟΓΙΑ
·
05.10.2013 - 12:47
Είναι ένα ακόμα βήμα σε μια ευρύτερη επιστημονική προσπάθεια διεθνώς για τη σταδιακή απεξάρτηση από τα ορυκτά καύσιμα, τόσο για οικονομικούς, όσο και για περιβαλλοντικούς…
Φιλικοί ιοί vs εχθρικά βακτήρια
ΥΓΕΙΑ
·
21.05.2013 - 09:21
Ευεργετική δράση μέσα στον ανθρώπινο οργανισμό μπορούν να έχουν φιλικοί ιοί, καταπολεμώντας «κακά» μικρόβια μαζί με το ανοσοποιητικό σύστημά μας, σύμφωνα με έρευνα Αμερικανών επιστημόνων.

Πιο βρώμικες από τις τουαλέτες οι κουζίνες στους χώρους εργασίας
ΥΓΕΙΑ
·
24.04.2013 - 22:58
Οι κουζίνες στους χώρους εργασίας είναι συνήθως τόσο βρώμικες, που θα μπορούσαν να προκαλέσουν μέχρι και ασθένειες, αναφέρει νέα έρευνα.

Τα ψυγεία αποτελούν εστίες μικροβίων
WHAT THE FACT
·
06.03.2013 - 22:02
Έρευνες έχουν δείξει ότι τα συρτάρια φρούτων και λαχανικών των οικιακών ψυγείων περιέχουν βακτήρια σε επίπεδα έως785 φορές υψηλότερα από το όριο ασφαλείας!

Ούτε που φαντάζεστε τι ζει μέσα στον αφαλό σας!
ΥΓΕΙΑ
·
30.01.2013 - 23:46
Ίσως φανεί περίεργο, όμως για τους βιολόγους, ο ανθρώπινος αφαλός παρουσιάζει πολύ μεγάλο ενδιαφέρον

Μάθετε τις 8 φωλιές μικροβίων
WHAT THE FACT
·
08.11.2012 - 21:56
Τα μικρόβια βρίσκονται σχεδόν παντού, μερικά όμως αντικείμενα συγκεντρώνουν μεγαλύτερη ποσότητα και για αυτό καλό θα ήταν ναφροντίζουμε να τα απολυμαίνουμε συχνότερα.

ΣΟΚ! Τα μικρόβια θα απομείνουν μοναδικοί κάτοικοι της Γης!
ΚΟΣΜΟΣ
·
04.11.2012 - 22:57
Η ζωή στον πλανήτη θα διατηρηθεί για τα επόμενα 2,8 δισεκατομμύρια χρόνια, σύμφωνα με τις προβλέψεις των επιστημόνων.

Το κινητό έχει περισσότερα μικρόβια από την τουαλέτα
WHAT THE FACT
·
22.05.2012 - 21:58
Μέχρι και 18 φορές περισσότερα επιβλαβή μικρόβια απ' ότι η λαβή σε ένα καζανάκι τουαλέτας μεταφέρει ένα μέσο κινητό τηλέφωνο, αναφέρουν βρετανοί ερευνητές.

Το πληκτρολόγιο που καθαρίζεται μόνο του
ΤΕΧΝΟΛΟΓΙΑ
·
10.01.2012 - 17:41
Όλοι γνωρίζουμε πως το πληκτρολόγιο του PC είναι φορέας μικροβίων, λόγω της καθημερινής χρήσης.

Είναι 40 φορές πιο μολυσμένο από μία δημόσια τουαλέτα. Τι είναι;
WHAT THE FACT
·
14.08.2011 - 06:50
Μια νέα μελέτη αποκαλύπτει ότι τα μπουτόν κλήσεως των ορόφων στα ασανσέρ...






